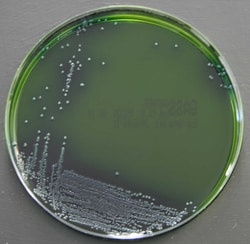
Thermo Scientific Milieu Gassner | Buy Online | Thermo Scientific&trade; | Fisher Scientific

Learn More
Thermo Scientific™ Milieu Gassner
Description
Détectez et isolez les entérobactéries pathogènes des échantillons alimentaires avec le milieu de Gassner Thermo Scientific™ Oxoid™. Il s’agit d’une modification du milieu de culture Gassner (lactose jaune métachrome bleu d’eau) d’origine1. Le milieu contient du jaune métachrome, ce qui inhibe la flore associée à Gram positifs. Les microorganismes à digestion de lactose tels que les espèces Escherichia coli ou Klebsiella forment des colonies bleues avec coloration bleue simultanée de la gélose environnante. Les microorganismes à lactose négatif, tels que les espèces Salmonella, Serratia ou Proteus, forment des colonies jaunes à fond jaune.
Utilisez le milieu Gassner pour la détection sélective et l’isolement des entérobactéries à partir de denrées alimentaires et d’autres échantillons.
- Sélectif : la présence de jaune métachrome inhibe la flore à Gram positifs non ciblée.
- Facilité de lecture : Les organismes positifs au lactose forment des colonies bleues alors que les organismes négatifs au lactose forment des colonies jaunes.
- Facilité d’utilisation des milieux de culture prêts à l’emploi
Les produits ne sont pas tous disponibles à la vente dans tous les pays. Veuillez nous contacter.
Les produits Remel™ et Oxoid™ font désormais partie intégrante de la marque Thermo Scientific

Spécification
Spécification
| Couleur | Vert olive |
| Contenu et stockage | 2°C à 10°C |
| Format | Plaque simple de 90 mm |
| Origine de la fabrication | Allemagne |
| Type de produit | Gélose |
| Poids plein | 17 g ± 5 % |
| Quantité | 10/paquet |
Veuillez fournir vos retours sur le contenu du produit en remplissant le formulaire ci-dessous.